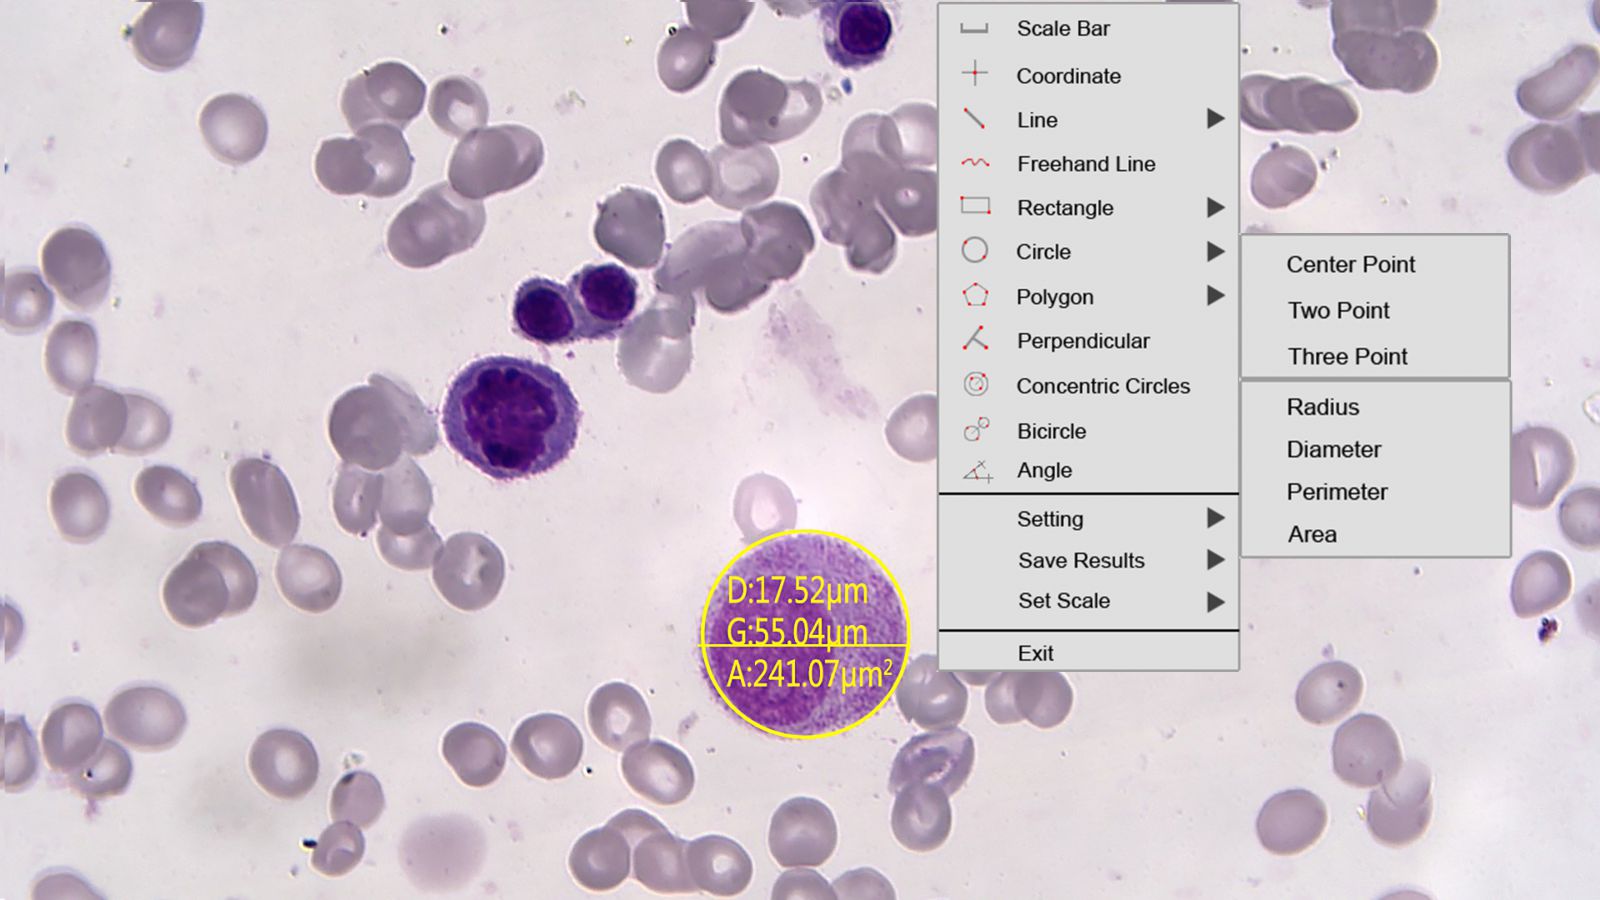

TrueChrome Metrics PC Software upgrade to Mosaic V2.1
Mosaic V2.1, Tucsen's new generation of computational imaging software, redefines the image acquisition - editing - measurement - report output workflow process, and provides two core functions: real-time image stitching and real-time depth of field expansion(EDF). Please click on the image below to learn more.
8 different localization options
TrueChrome Metrics allows free switching of eight local languages, including English, Chinese Simplified, Traditional Chinese, German, Italian, French, Korean and Japanese.
.jpg)
A variety of efficient measurement tools to achieve micron-level precision measurement
TrueChrome Metrics is equipped with a variety of measuring tools such as free line, rectangle, circle, polygon, dotted line, concentric circle, double circle, angle and so on. It can realize the precision of microns such as line distance, angle, length, circumference, area Measurement, the data can be accurate to 1/100 microns, very small cells can be measured very accurately.
Variety of measurement applications
In addition to microns, TrueChrome Metrics also supports millimeters, centimeters of up to two orders of magnitude and can fully meet the needs of users under different scenarios of diverse measurement applications. It provides the user high productivity quantitative analysis via an intuitive interface.
.jpg)
Convenient measurement data management
TrueChrome Metrics supports both Excel and text file save formats. This results in convenience for measurement data management.

The essence of TrueChrome II continues
30 frames per second high speed image
TrueChrome Metrics achieves 30 frames/sec uncompressed data transfer at 1920x1080 resolution and is the world's fastest USB 2.0 camera.


Excellent fluorescence imaging
TrueChrome Metrics uses a high signal-to-noise ratio image sensor which can achieve up to a 10 second exposure capable of capturing excellent fluorescence images.
3D noise reduction function
The powerful 3D noise reduction feature effectively reduces the noise, so that even with long exposures in low light the image remains crisp and free of noise.
.png)

1080P Video Recording
Click the button to shoot 1080P 30fps video. The video file is stored on a high-speed SD card and can also be viewed live.
Highly intelligent
The TrueChrome Metrics automatically captures image information and presents the perfect image with the best white balance, exposure, and saturation. Whether it's a bright field or a dark field, the image fidelity is perfect without the need for manual adjustments.
.png)
.png)
Simple Operation
The TrueChrome Metrics start screen has only two buttons, a camera, and a setup menu which makes it extremely easy to use.

















